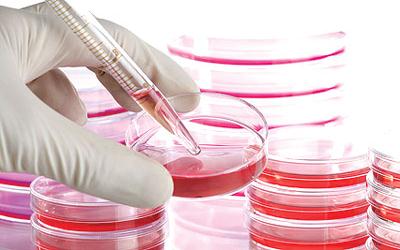

يعكف علماء فرنسيون فى أكاديمية طبية وجراحية على بنك للكبد عن طريق البناء الذاتى من خلال الخلايا الجذعية المصنعة مع مجموعة من الدم والأنسجة لحل مشكلة زرع الأعضاء التى تعانى من قحط شديد بعدم وجود متبرعين والسبب فى وفاة 500 فرنسى سنويا فى انتظار عملية زرع الاعضاء.
وأشارت الدراسات العلمية إلى أن البناء الذاتى للكبد سوف يتم عن طريق الخلايا الجذعية المأخوذه من الألياف السليمة للمريض كما تجرى الأبحاث على الكلى حيث أن هذا العضو أكثر تعقيدا حيث يتكون من 26 نوعا من الخلايا ويقدم العديد من الخدمات للجسم تنقية الدم وإفراز الهرمونات.
أما بالنسبة للرئة فالأبحاث مازالت بعيدة حيث إنها تحتاج لنظام قادر على التبادل فى عملية التنفس للاوكسجين وثانى أكسيد الكربون وهذه الابحاث تحتاج إلى20 عاما من الدراسة والبحث.

أضف تعليق